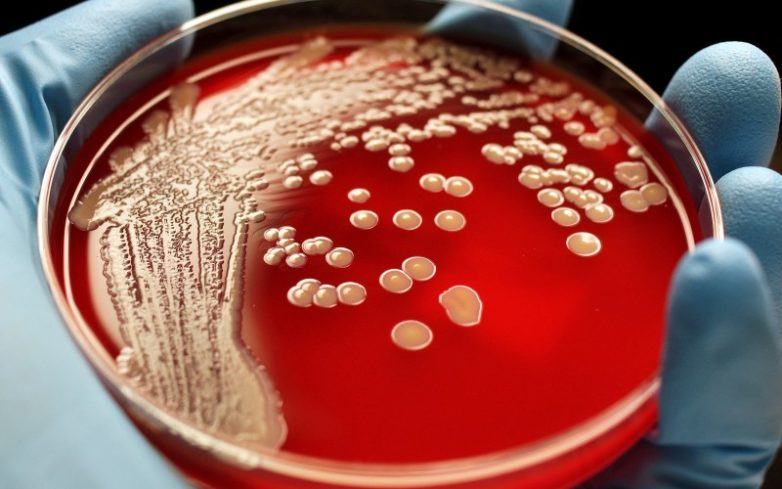

Эти 10 примеров эволюции происходят прямо сейчас. Вот это да!
Изменяя ландшафт, превращая дикую местность в пригороды, создавая гибриды и способствуя появлению устойчивых к ядам вредителей и супермикробов, человек творит эволюцию прямо на наших глазах.

Хотя современные собаки отдалились от своего волчьего предка около 18 тысяч лет назад, в течение последних 150 лет щенки бродячих собак становятся все больше похожи на волков. Бездомным собакам, чтобы научиться выживать на улицах, приходится нестись по эволюционной лестнице большими скачками, отбирая и передавая лучшие качества своим детенышам. Это хороший пример того, что происходит, когда двигатель эволюционного процесса, в лице человека в данном случае, внезапно исчезает.
Еще тысячелетия назад наши предки, жившие в пещерах, были прекрасно знакомы с проблемой клопов. К сожалению, когда люди переселились в города, клопы мигрировали вслед за ними. Наша социальная эволюция буквально подстегнула естественную эволюцию этих отвратительных насекомых. Городские клопы перешли на ночной образ жизни, отрастили более длинные ноги для прыжков. Более толстый, чем у их пещерных предков, экзоскелет и ускоренный обмен веществ гарантируют эффективную защиту от пестицидов.

Как правило, представители разных видов не могу скрещиваться друг с другом и давать плодовитое потомство. Это касается и мышей, но 50 лет назад 2 вида смогли преодолеть барьер, поставленный самой природой. Алжирские и домовые мыши скрещиваясь, смогли дать плодовитое потомство. Это было возможно только при единственно верном сочетании генов. Новый гибрид получил от предков ценный дар: кусок генетического кода делает грызунов невосприимчивыми к яду варфарину, исключая летальный эффект от пестицидов для этих мышей.

Как выжить, если долгие месяцы единственным источником энергии остается только солнце? Морские слизни знают ответ на этот вопрос: украсть часть полезных генов у растений. Заглатывая куски водорослей, которыми питаются слизни, они встраивают растительные гены в свой генетический код. С их помощью полуживотные-полурастения могут продуцировать хлоропласты – клеточные структуры, улавливающие и преобразующие энергию солнца. Таким образом, морские слизняки игнорируют традиционную эволюцию, и являются одним из очень немногих примеров такого процесса, как горизонтальный перенос генов.

Используя искусственный отбор человек смог сделать из далекого предка современных собак ценного союзника. При помощи отбора люди не создали новые виды собак, а просто развели кучу пород. Однако наши действия все-таки не могут не оказывать влияния на собачий геном. Изменения, например, происходят, когда заводчики скрещивают разные породы, чтобы получить таких забавных собак, как лабрадудель (гибрид лабрадора и пуделя) или кокапу (смесь кокер спаниеля и пуделя).

Бабочку пяденицу обычно легко заметить на темной поверхности: у нее белые крылья с крошечными темными пятнами. Во время промышленной революции в Англии и США обилие свежеиспеченных фабрик поставило существование пядениц под угрозу. Светлый окрас бабочек был хорошо заметен для хищников на покрытых сажей улицах. Спустя несколько поколений бабочки смогли полностью поменять свою расцветку на темную. Когда в 70-х годах прошлого века принятые меры по борьбе с загрязнением среды уменьшили количество сажи, потемневшие бабочки опять стали слишком заметны. И несчастным пяденицам не оставалось ничего другого, кроме как вернуться к своему первоначальному светлому окрасу.

Новый хищник гибрид койота и волка, или койвольф, впервые появился несколько десятилетий назад на северо-восточной территории США. Койвольф вряд ли бы появился, если бы фермеры и охотники не вынудили уйти его предков из их естественных мест обитания. ДНК волков позволяет гибридам охотиться на крупную добычу сообща, в то время как ДНК койотов помогает им быстрее адаптироваться в городской среде. Эти крупные, весом до 70 кг, звери лучше приспособлены к своему месту обитания, чем их предки, а значит, смогут и дальше стабильно увеличивать свою численность.

Около 75 лет назад австралийское сахарное бюро решило вывезти несколько южноамериканских тростниковых жаб из Гавайев в Австралию. По их замыслу жабы должны были избавить сахарные плантации от жуков, пожирающих тростник. В новой среде, где у жаб не было естественных врагов, их популяции ничего не оставалось, кроме как расти в геометрической прогрессии. По сравнению со своими предками, австралийские жабы имеют более длинные ноги и могут совершать прыжки на большее расстояние. Благодаря таким эволюционным усовершенствованиям, эти земноводные стремительно распространились по всей Австралии.

Растение из ЮАР, часто именуемое как крысиный хвост, специально для удобства опыляющих его птиц, вырастило жесткий вертикальный ствол. Птица садится на ствол, свешивается вниз головой, чтобы попить нектар, и попутно опыляет цветок. Необычное эволюционное нововведение связано с тем, что птицы боятся приближаться к земле, опасаясь хищников. А полностью зависящие от птиц-опылителей растения постарались сделать опыление для птиц максимально комфортным. С чем они и справились блестяще.

Недавно врачи обнаружили, что некоторые виды микроорганизмов, вызывающих инфекции, стали устойчивы даже к самым сильным антибиотикам. Выработав такую потрясающую защиту, они, с точки зрения генетики, нас перехитрили. Механизм защиты от лекарств передается микроорганизмами следующим поколениям, ставя под угрозу наше существование. Согласно имеющимся у инфекционного общества здравоохранения данным, из-за устойчивых к антибиотикам бактерий может умереть до 350 миллионов человек к 2050 году.
Бродячие псы

Хотя современные собаки отдалились от своего волчьего предка около 18 тысяч лет назад, в течение последних 150 лет щенки бродячих собак становятся все больше похожи на волков. Бездомным собакам, чтобы научиться выживать на улицах, приходится нестись по эволюционной лестнице большими скачками, отбирая и передавая лучшие качества своим детенышам. Это хороший пример того, что происходит, когда двигатель эволюционного процесса, в лице человека в данном случае, внезапно исчезает.
Клопы

Еще тысячелетия назад наши предки, жившие в пещерах, были прекрасно знакомы с проблемой клопов. К сожалению, когда люди переселились в города, клопы мигрировали вслед за ними. Наша социальная эволюция буквально подстегнула естественную эволюцию этих отвратительных насекомых. Городские клопы перешли на ночной образ жизни, отрастили более длинные ноги для прыжков. Более толстый, чем у их пещерных предков, экзоскелет и ускоренный обмен веществ гарантируют эффективную защиту от пестицидов.
Устойчивые к пестицидам мыши

Как правило, представители разных видов не могу скрещиваться друг с другом и давать плодовитое потомство. Это касается и мышей, но 50 лет назад 2 вида смогли преодолеть барьер, поставленный самой природой. Алжирские и домовые мыши скрещиваясь, смогли дать плодовитое потомство. Это было возможно только при единственно верном сочетании генов. Новый гибрид получил от предков ценный дар: кусок генетического кода делает грызунов невосприимчивыми к яду варфарину, исключая летальный эффект от пестицидов для этих мышей.
Морские разбойники

Как выжить, если долгие месяцы единственным источником энергии остается только солнце? Морские слизни знают ответ на этот вопрос: украсть часть полезных генов у растений. Заглатывая куски водорослей, которыми питаются слизни, они встраивают растительные гены в свой генетический код. С их помощью полуживотные-полурастения могут продуцировать хлоропласты – клеточные структуры, улавливающие и преобразующие энергию солнца. Таким образом, морские слизняки игнорируют традиционную эволюцию, и являются одним из очень немногих примеров такого процесса, как горизонтальный перенос генов.
Породы собак

Используя искусственный отбор человек смог сделать из далекого предка современных собак ценного союзника. При помощи отбора люди не создали новые виды собак, а просто развели кучу пород. Однако наши действия все-таки не могут не оказывать влияния на собачий геном. Изменения, например, происходят, когда заводчики скрещивают разные породы, чтобы получить таких забавных собак, как лабрадудель (гибрид лабрадора и пуделя) или кокапу (смесь кокер спаниеля и пуделя).
Пяденица и индустриализация

Бабочку пяденицу обычно легко заметить на темной поверхности: у нее белые крылья с крошечными темными пятнами. Во время промышленной революции в Англии и США обилие свежеиспеченных фабрик поставило существование пядениц под угрозу. Светлый окрас бабочек был хорошо заметен для хищников на покрытых сажей улицах. Спустя несколько поколений бабочки смогли полностью поменять свою расцветку на темную. Когда в 70-х годах прошлого века принятые меры по борьбе с загрязнением среды уменьшили количество сажи, потемневшие бабочки опять стали слишком заметны. И несчастным пяденицам не оставалось ничего другого, кроме как вернуться к своему первоначальному светлому окрасу.
Койвольфы

Новый хищник гибрид койота и волка, или койвольф, впервые появился несколько десятилетий назад на северо-восточной территории США. Койвольф вряд ли бы появился, если бы фермеры и охотники не вынудили уйти его предков из их естественных мест обитания. ДНК волков позволяет гибридам охотиться на крупную добычу сообща, в то время как ДНК койотов помогает им быстрее адаптироваться в городской среде. Эти крупные, весом до 70 кг, звери лучше приспособлены к своему месту обитания, чем их предки, а значит, смогут и дальше стабильно увеличивать свою численность.
Жабы-путешественницы

Около 75 лет назад австралийское сахарное бюро решило вывезти несколько южноамериканских тростниковых жаб из Гавайев в Австралию. По их замыслу жабы должны были избавить сахарные плантации от жуков, пожирающих тростник. В новой среде, где у жаб не было естественных врагов, их популяции ничего не оставалось, кроме как расти в геометрической прогрессии. По сравнению со своими предками, австралийские жабы имеют более длинные ноги и могут совершать прыжки на большее расстояние. Благодаря таким эволюционным усовершенствованиям, эти земноводные стремительно распространились по всей Австралии.
Живой насест

Растение из ЮАР, часто именуемое как крысиный хвост, специально для удобства опыляющих его птиц, вырастило жесткий вертикальный ствол. Птица садится на ствол, свешивается вниз головой, чтобы попить нектар, и попутно опыляет цветок. Необычное эволюционное нововведение связано с тем, что птицы боятся приближаться к земле, опасаясь хищников. А полностью зависящие от птиц-опылителей растения постарались сделать опыление для птиц максимально комфортным. С чем они и справились блестяще.
Стойкие бактерии
Недавно врачи обнаружили, что некоторые виды микроорганизмов, вызывающих инфекции, стали устойчивы даже к самым сильным антибиотикам. Выработав такую потрясающую защиту, они, с точки зрения генетики, нас перехитрили. Механизм защиты от лекарств передается микроорганизмами следующим поколениям, ставя под угрозу наше существование. Согласно имеющимся у инфекционного общества здравоохранения данным, из-за устойчивых к антибиотикам бактерий может умереть до 350 миллионов человек к 2050 году.
Только зарегистрированные и авторизованные пользователи могут оставлять комментарии.
-2
Нет никакой эволюции, происходит только эволюция наших знаний. В природе естественная эволюция невозможна.
- ↓
+3
Эволюцию остановить нельзя! Её можно только прервать!
- ↓

